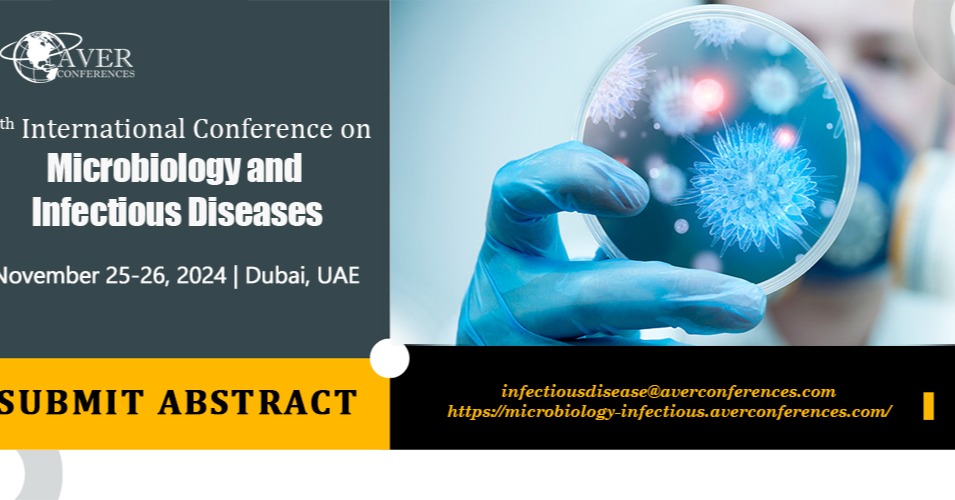

Microbiology & Infectious congress 2024 will be held on November 25-26, 2024 in Dubai, UAE. Microbiology & Infectious Diseases Conference accepts abstracts on research work, case reports, review papers, clinical experience and more.
Microbiology & Infectious congress 2024 brings together the global leaders in Microbiology & Infectious Diseases fields to present their research at this exclusive scientific program. The conference delivers an opportunity to researchers and experts to discover the basic, innovative and latest research developments in the field of Current Trends in Microbiology and Infectious Diseases.
Microbiology & Infectious congress 2024 brings together the global leaders in Microbiology & Infectious Diseases fields to present their research at this exclusive scientific program. The conference delivers an opportunity to researchers and experts to discover the basic, innovative and latest research developments in the field of Current Trends in Microbiology and Infectious Diseases.
Target Audience
- Microbiology & Infectious Diseases Researchers
- Microbiology & Infectious Diseases Scientists, Students
- Microbiology & Infectious Diseases Faculty
- Microbiology & Infectious Diseases Associations and Societies